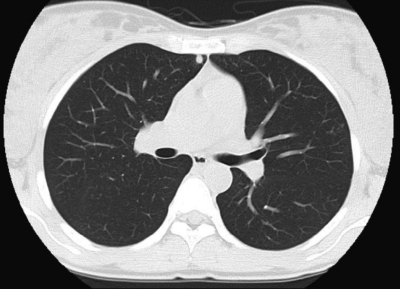
#

31歳の女性。1回経妊0回経産婦。胞状奇胎の治療後に妊娠反応陽性が持続するため紹介されて来院した。1年前から不妊外来で排卵誘発薬の投与を受けていた。3か月前に妊娠反応陽性となったが、全胞状奇胎と診断され2回の子宮内容除去術を受けた。基礎体温は1相性である。
内診で子宮はやや腫大、軟。超音波検査で後壁筋層内に血流豊富な径 1.5 cm の腫瘤を認める。脳、肝、腎臓および腟に異常を認めない。血清 hCG の推移と肺野条件の胸部 CTとを別に示す。
治療として適切なのはどれか。
a. 手術療法
b. 放射線療法
c. ホルモン療法
d. 抗癌化学療法
e. 分子標的薬投与